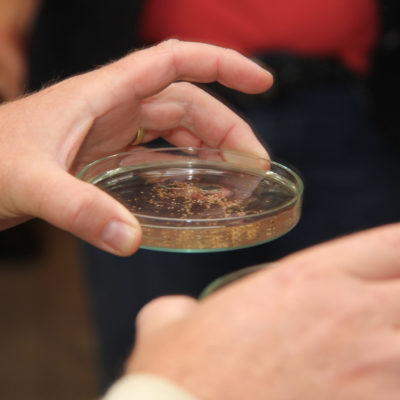

28. September 2018
Start für Aufzucht der Flussperlmuschel

Startschuss im Landkreis Hof für die Zucht der Flussperlmuschel: Ab jetzt wird in der Huschermühle im Dreiländereck bei Regnitzlosau für den Erhalt der vom Aussterben bedrohten Tierart gesorgt. Ulrich Scharfenberg, Kreisvorsitzender des Bund Naturschutz und Wolfgang Degelmann, Geschäftsführer des Bund Naturschutz und Leiter der Zuchtanlage, haben Landrat Dr. Oliver Bär und mehreren Kreisräten das Projekt vorgestellt.

Neun Monate hat der Umbau der Huschermühle zur Flussperlmuschelzuchtanlage gedauert. Die als Wirtfische dienenden Forellen waren zwischenzeitlich in der Lehranstalt für Fischerei des Bezirks Oberfranken in Aufseß im Landkreis Bayreuth ausgelagert. Nun kehren sie in die Becken der neuen Aufzuchtanlage zurück. Dort werden die Kiemen der Forellen mit den mikroskopisch kleinen Larven der Flussperlmuschel – den sogenannten Glochidien – infiziert, wo sie für rund ein Jahr als Parasiten leben, bis sie von selbst abfallen. Das Ganze ist für die Fische völlig ungefährlich. In speziellen Behältern werden die jungen Muscheln dann im Bachwasser gehalten, bis sie bei einer Größe von etwa 15 Millimetern in die Freiheit entlassen werden.

Laut Ulrich Scharfenberg dient die Aufzuchtanlage als Zeitgewinnungsprojekt für die kommenden Jahre. Erst wenn sich die Lebensverhältnisse für die Jungmuscheln in den Bächen zum Positiven verändert hätten, könne man daran denken, die Vermehrung wieder komplett der Natur zu überlassen. Das größte Problem ist laut Scharfenberg die Sedimentschicht, die sich durch die jahrzehntelange Verschmutzung der Bäche mit industriellen Abwässern und durch die Düngung in der unmittelbaren Nähe der Gewässer, gebildet hat. Die von den Forellen abfallenden Jungmuscheln versinken in der Sedimentschicht und ersticken. Zwar laufen in dieser Richtung schon einige Projekte wie das Wegbaggern der Schicht, allerdings seien die Gespräche mit Verursachern aus der Landwirtschaft teilweise recht zäh, so Scharfenberg.

Etwa 5000 bis 8000 Jungmuscheln sollen pro Zyklus in der Huschermühle gezüchtet werden, das wären pro Jahr etwa 15.000 bis 24.0000 Tiere. Die Kosten für das 1,37 Millionen Euro teure Projekt übernehmen zu 85 Prozent die Europäische Union, 5 Prozent der Bayerische Naturschutzfonds und 10 Prozent die BN Kreisgruppe Hof.